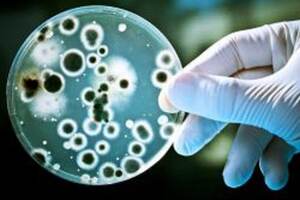

Recommended
Президент Шавкат Мирзиёев Остона шаҳрида Осиёда ҳамкорлик ва ишонч чоралари бўйича кенгашнинг олтинчи саммитида нутқ сўзламоқда.
12:09 13 Октябр 2022Жо Байденнинг миллий хавфсизлик бўйича маслаҳатчиси Жейк Салливан Хитойни АҚШ учун энг муҳим геосиёсий муаммо деб атади.
00:03 13 Октябр 20222022 йилнинг 12-октябрь куни Остона шаҳрида Қозоғистон Республикаси раислигида Мустақил Давлатлар Ҳамдўстлиги Ташқи ишлар вазирлари Кенгашининг навбатдаги йиғилиши бўлиб ўтди.
23:28 12 Октябр 2022"Жаҳон тўқимачилик бозоридаги янги мувозанат - янги иштирокчилар ва тенденциялар" мавзусида Тошкент тўқимачилик саммитидан Фоторепортаж
19:30 12 Октябр 2022Америка Қўшма Штатлари Украинада Россия билан эҳтимолий ҳарбий можаронинг кучайишини истамайди ва Украина ҳудудига ўз қўшинларини юбормоқчи эмас.
23:50 11 Октябр 2022АҚШ расмийларига кўра, жанговар ҳаракатлар тугаши фақат Киевга боғлиқ. Украинани музокаралар столига мажбурлаб олиб келиб бўлмайди.
23:32 11 Октябр 2022Ўрта ер денгизи парҳези саратон иммунотерапиясига жавобни яхшилайди
00:30 11 Октябр 2022Айрим Европа давлатларининг қурол-яроғ захиралари Украинага етказиб берилаётган таъминот туфайли тугаб бормоқда.
23:23 10 Октябр 2022"Qanot Sharq" маҳаллий авиакомпанияси томонидан лизингга сотиб олинган иккита самолётдан бири Airbus A321neo пойтахт аэропортига етиб келди.
17:17 10 Октябр 2022Дзюдо бўйича катталар ўртасидаги 35-жаҳон чемпионатининг тантанали очилиш маросимидан Фоторепортаж
00:36 10 Октябр 2022Россиянинг йирик шаҳарларида Янги йил тадбирлари бекор қилинмоқда ва тежалган маблағлар эса қисман сафарбарликка йўналтирилади
00:25 08 Октябр 2022Жаҳон соғлиқни сақлаш ташкилоти шу кунларда инсоният яна бир хавфли эпидемия билан юзлашиши эҳтимолидан жиддий ташвишда ва бунга етарлича асослар ҳам бор.
22:31 07 Октябр 2022Беларусь президенти Александр Лукашенко Россия президенти Владимир Путиннинг 70 ёшга тўлиши муносабати билан BELARUS тракторини совға қилди.
18:27 07 Октябр 2022Оролбўйи минтақаси юзасидан юборилган парламент сўровига ҳукуматнинг жавоби қандай бўлди?
15:36 07 Октябр 2022Маҳаллийлаштириш дастурларининг ижро ҳолати сенаторлар муҳокамасида
15:20 07 Октябр 2022Инвестиция лойиҳаларини амалга ошириш ҳамда тадбиркорликни ривожлантириш борасидаги ишлар муҳокама қилинди
14:53 07 Октябр 2022Янги иш ўринларини яратиш ҳамда аҳоли бандлигини таъминлаш борасидаги ишлар муҳокама қилинди
14:01 07 Октябр 2022Сенаторлар ногиронлиги бўлган шахсларнинг ижтимоий ҳимоясини янада кучайтирувчи қонунни маъқуллади
12:07 07 Октябр 2022Географик объектларга ном бериш талаблари такомиллаштирилмоқда
11:54 07 Октябр 2022Кўп ўқилганлар
- “Ўтган баҳсда концентрация бироз жойида эмас эди. Шу сабабли “жиннича” хатоларга йўл қўйдик” — Фабио Каннаваро
- АҚШ мудофаа харажатлари туфайли НАТО бўйича иттифоқчиларини ҳимоя қилишдан воз кечиши мумкин
- Бен Кингсли иштирок этган Ислом цивилизацияси маркази ҳақидаги фильм New York Festivals 2026 финалига йўл олди
- Шавкат Мирзиёев Саудия Арабистони Подшоҳлиги Валиаҳди Муҳаммад бин Салмон Ол Сауд билан телефон орқали мулоқот қилди
- Тошкентда қиличбозликнинг сабля йўналиши бўйича Жаҳон кубоги босқичи старт олди
- «Дронлар дуэли» ёхуд Украинадан Эронгача бўлган синов полигонларида шаклланган янги дунё тартиби